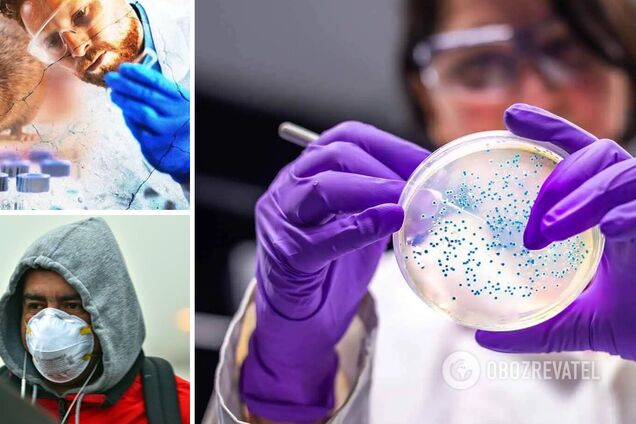
На Львовщине за последние два года зафиксировали второй случай хантавируса

Не COVIDом единым. Врачи раскрыли правду о хантавирусе в Украине и сказали, как уберечься
После начала пандемии COVID-19 в мире стали активно распространяться новости об опасных болезнях, которые передаются от животного к человеку. Один из таких – хантавирус, переносчиком которого являются грызуны. Еще в ноябре 2020 года первый случай инфицирования обнаружили в Европе, а теперь, похоже, он добрался и до Украины.
В чем кроется опасность вируса, какие симптомы являются индикаторами болезни и что делать, чтобы не заразиться – читайте в материале OBOZREVATEL.
О первых случаях хантавируса заявили на Львовщине
Хантавирус – редкое вирусное заболевание, которое передается людям при контакте с мочой, экскрементами или слюной инфицированных грызунов.
Главный санитарный врач Львовской области, эпидемиолог Наталья Тимко рассказала, что в регионе столкнулись с вирусом уже дважды:
В 2019 году, когда заразился студент со Львова;
В конце 2020-го, когда его обнаружили у жителя Дрогобычского района.
По словам врача, 11 декабря в областную инфекционную больницу поступил мужчина старше 40 лет. Его симптомы:
высокая температура;
мелкие кровоизлияния;
уменьшение количества мочи;
боли в пояснице и мышцах.
Сначала у врачей было подозрение на лептоспироз – тоже инфекционное заболевание, которое имеет похожие клинические признаки. Потом подумали, что у больного геморрагическая горячка. Однако при обследовании решили проверить еще и на хантавирус, сдав анализы в вирусологическую лабораторию Центра общественного здоровья в Киеве. Больного тестировали дважды с разницей в 10 дней. На второй раз помимо самой инфекции медики обнаружили формирование антител к ней.
Уже к Новому году мужчина полностью оправился. Позже стало известно, что от грызунов ему "повезло" заразиться во время выполнения хозяйственных работ.
Что касается первого случая, то студент, по словам Тимко, мог "найти" вирус в специях, которые покупал на одном из базаров.
"Посыпал ими пищу и ел без термической обработки. Была версия, что в пряностях могли находиться контаминированные выделения грызунов и таким образом парень мог подцепить инфекцию. Поэтому людям стоит покупать или упакованные товары или же проводить термическую обработку. Иначе будет риск", – рассказала эпидемиолог.
Это не коронавирус, но нужно быть аккуратными
Главное:
Крысы и мыши сами не болеют, а лишь переносят инфекцию.
Симптомы похожи на грипп и ОРВИ, иногда – на коронавирус.
В редких случаях все же есть угроза летального исхода.
Официально фиксировать пациентов с хантавирусом нет возможности.
Украинские эпидемиологи успокаивают: хантавирус – не COVID-19, у него нет способности передаваться воздушно-капельным путем. Значит, о массовом распространении инфекции между людьми речь не идет.
"Человек вылечился и все. Вирус никуда не передался, вспышки быть не может. Единственное, за кем следует проследить, – так это за людьми, которые живут с инфицированным, не заразились ли они тем же путем, что и больной. Бывает, что в Украине фиксируют случаи хантавируса, но они единичны. Заражаются через контакты со стулом грызунов", – говорит OBOZREVATEL эпидемиолог Людмила Мухарская.
Инфекционист, врач высшей категории Юрий Жигарев отмечает, что грызуны, хоть и являются носителями вируса, сами не болеют.
"Я считаю, что такие пациенты [с хантавирусом] у нас есть, потому что есть соответствующие природные условия, чтобы эти инфекции существовали. Но мы их не подтверждаем, потому что это не просто сделать: исследовать и сказать, что это именно хантавирус. Нет характерных признаков, по которым можно было просто осмотреть пациента и сделать выводы, что у человека именно это заболевание", – рассказывает он.
По словам Жигарева, первые симптомы хантавируса могут напоминать респираторную инфекцию: слабость, повышение темпетаруты, кашель.
"В случае более тяжелого течения болезни может быть пневмония и дыхательная недостаточность. Сейчас это может скрываться под маской коронавирусной инфекции, ведь симптомы бывают похожи. Коварство в том, что в некоторых случаях этого заболевания может возникать почечная недостаточность. Одна из клинических форм так и называется – лихорадка с почечным синдромом. То есть у заболевшего отказывают почки, и, если вовремя не оказать медицинскую помощь, человек может умереть" – предупредил кандидат медицинских наук.
А Наталья Тимко добавляет: чтобы уберечься от инфицирования, при работе на земле или в подвалах надо надевать защитные перчатки, а на фермерских хозяйствах истреблять грызунов. Также после работы в земле следует очень тщательно мыть руки с мылом.
Что еще известно о хантавирусе:
Хантавирус впервые обнаружили в 1970-х годах. Первичными его носителями являются оленьи мыши. Также возбудитель обнаружили у западной полевой мыши и хлопковой крысы.
У инфицированных грызунов развивается хроническая инфекция, а сам возбудитель выделяется со слюной и мочой. Эпидемиологи отмечают, что люди могут заразиться хантавирусом только от грызунов, случаев передачи от человека к человеку не было.
У больных начинается жар, возможны кровотечения, задержка мочи. В первые дни заражения человек может испытывать головную боль, кашель, слабость.
Инкубационный период вируса длится одну-две недели. Смерть может наступить из-за инфекционно-токсического шока и острой дыхательной недостаточности.
Хантавирус чаще встречается в Канаде, США, Аргентине, Бразилии, Чили, Панаме.
В марте 2020 года от хантавируса умер житель Китая. Трагедия произошла, когда он ехал в общественном транспорте, пассажиру резко стало плохо.











